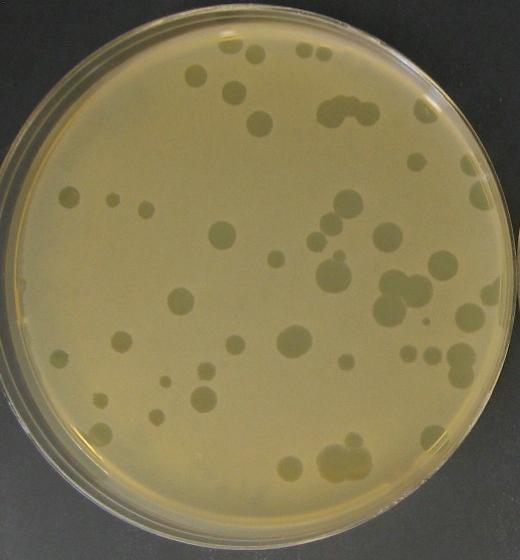

Pan con menos calorías gracias a la ciencia
Una investigación del Consejo Superior de Investigaciones Científicas (CSIC) ha permitido crear un pan con un 45 por ciento menos de calorías. Según las autoras de este nuevo proceso, además de reducir la cantidad...
Un experimento para `ver´ la evolución a cámara rápida
Un grupo de investigadores de la Universidad Estatal de Michigan (EEUU) ha realizado un paciente experimento de nada menos que 25 años de duración, a lo largo de los cuales se han analizado más de 50.000 generaciones...
Científicos Argentinos desarrollan procesos de perfeccionamiento de las baterías de litio
El Dr. César Barbero, de la Universidad Nacional de Río Cuarto, explicó detalles del trabajo que lleva adelante junto con su equipo de investigación en los componentes del carbono, que servirán para mejorar las...
Avance Argentino en la lucha contra la fiebre amarilla
Encontraron una proteína que inhibe el virus de fiebre amarilla. También podría actuar contra el VIH, la hepatitis C y el dengue
Un equipo de investigadores de nuestro país demostró que la proteína que envuelve...
Médicos proponen usar cepas de virus para combatir bacterias del acné
Médicos de la Universidad de California explican que ahora se sabe que la principal causa del acné son las bacterias, aunque reconocen que las hormonas sexuales, el aceite facial y el sistema inmunológico juegan...
Investigadores Argentinos desarollan y patentan dos sistemas que eliminan el arsénico y el flúor de aguas subterráneas
En el Centro de Ingeniería Sanitaria de la Facultad de Ingeniería y Agrimensura se trabaja sobre dos líneas de investigación: el agua potable y la disposición de las excretas o tratamientos de líquidos residuales....